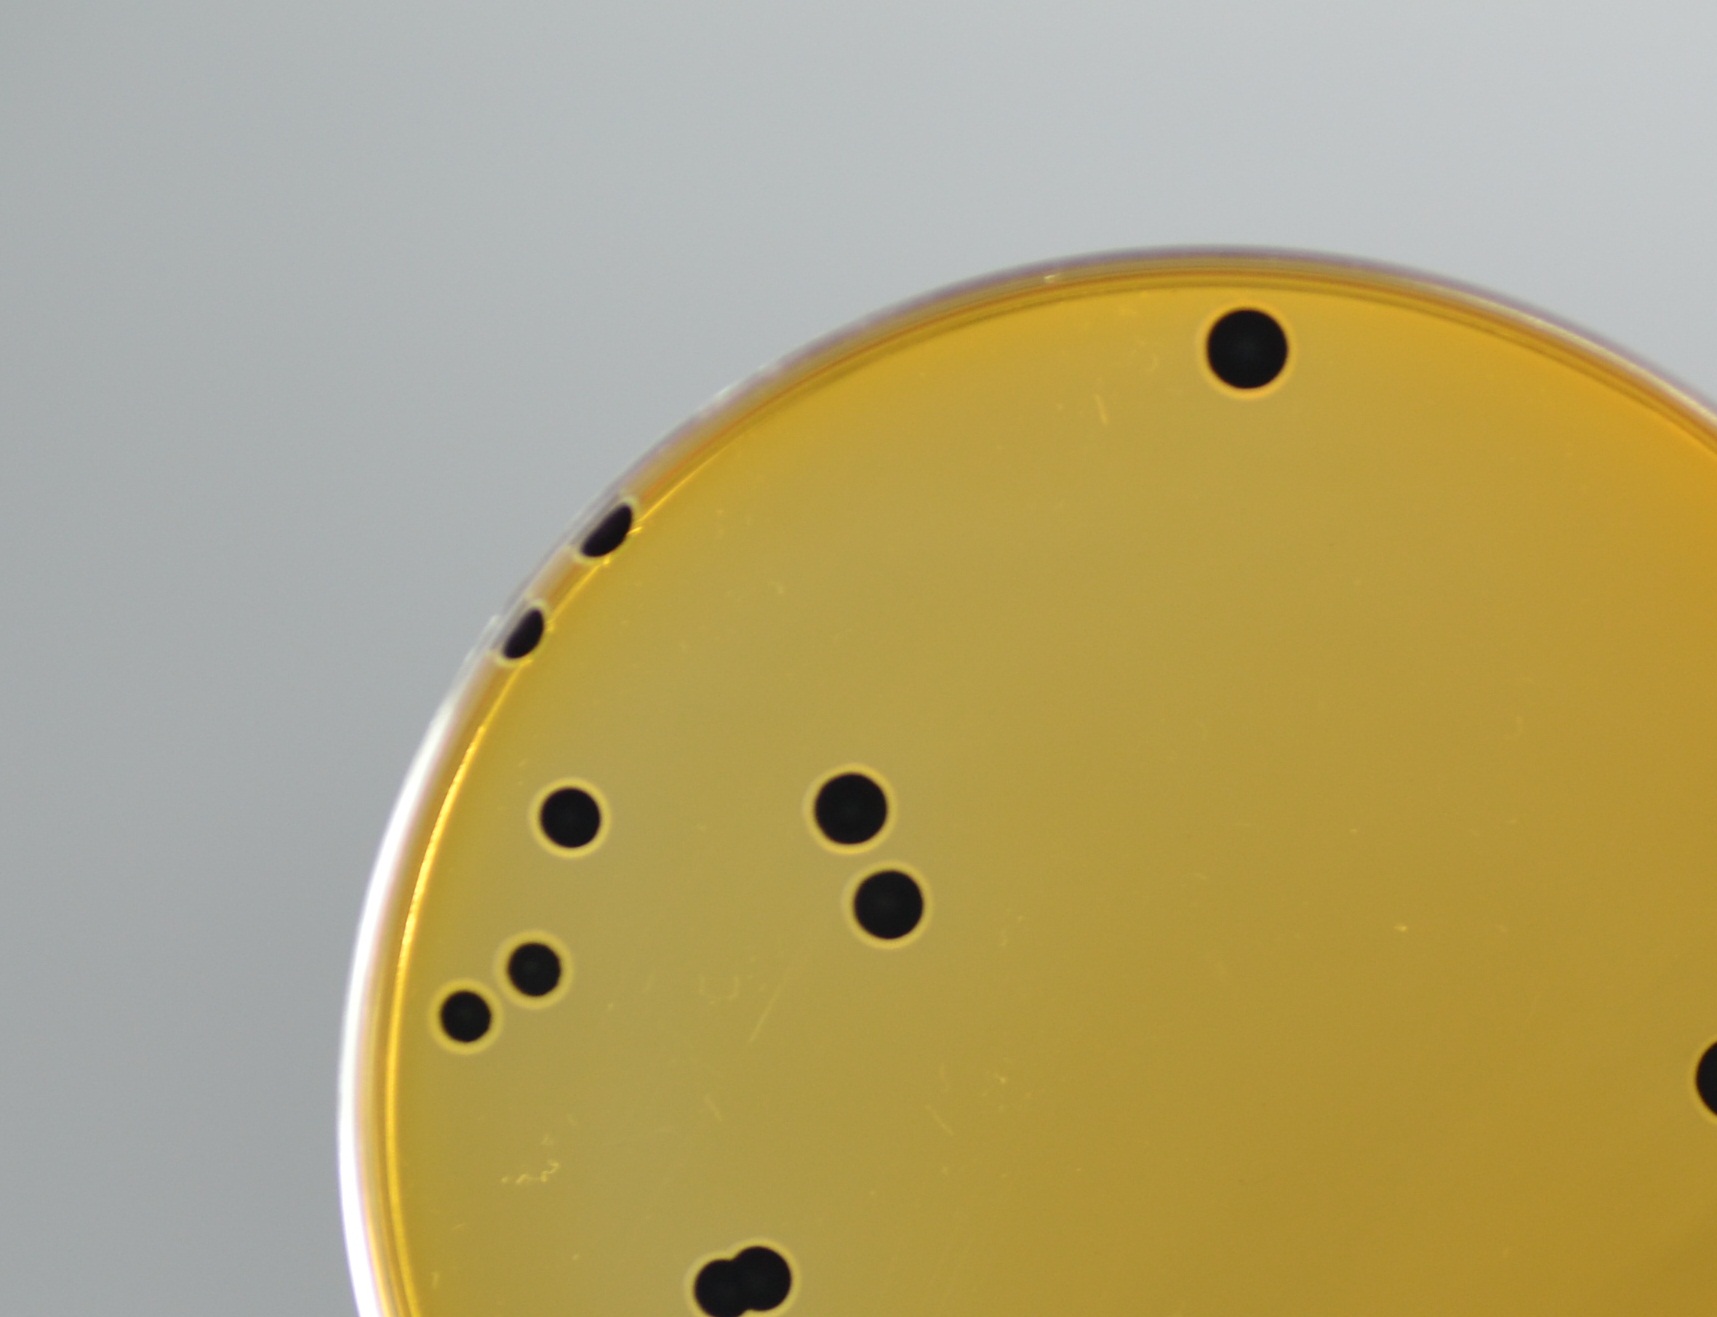

INFORMATION CENTER
首頁 / 信息中心 / 行業(yè)新聞

前言:3月28日,第一屆中國綠色生物制造峰會(huì)于廣州舉行,共議合成生物技術(shù)應(yīng)用新模式、新技術(shù)和新思路。綠色生物制造是實(shí)現(xiàn)可持續(xù)發(fā)展的重要途徑,需要各界加強(qiáng)技術(shù)創(chuàng)新和產(chǎn)業(yè)合作,推動(dòng)綠色...
2023-04-13 [詳情]
2023年2月27日,第六屆全球物聯(lián)網(wǎng)黑科技大賽總決賽成功舉行,來自工業(yè)互聯(lián)網(wǎng)、智能制造、智慧醫(yī)療、智慧城市賽道的19個(gè)項(xiàng)目同場(chǎng)競(jìng)技。 ...
2023-03-23 [詳情]
防病微生物菌肥的發(fā)展?fàn)顩r Science & Technology 防病微生物菌肥屬于我國微生物肥料發(fā)展中的第四代產(chǎn)品,是生防促生微生物作為主要菌種...
2023-03-01 [詳情]
北京君立康工作人員在作業(yè)。 ...
2021-05-20 [詳情]
各設(shè)區(qū)市、贛江新區(qū)、省直管試點(diǎn)縣(市)市場(chǎng)監(jiān)管局: 現(xiàn)將《江西省小餐飲小食雜店小攤販專項(xiàng)整治工作方案》印發(fā)給你們,請(qǐng)認(rèn)真貫徹執(zhí)...
2021-05-13 [詳情]
4月29日,河北邢臺(tái)市委副書記、代市長(zhǎng)宋華英主持召開市政府食品藥品安全委員會(huì)全體會(huì)議,深入學(xué)習(xí)貫徹習(xí)近平總書記關(guān)于食品安全工作重要論述,落實(shí)國務(wù)院、省政府食品安全委員會(huì)會(huì)議精神...
2021-05-13 [詳情]
2020年8月18日,省市場(chǎng)監(jiān)管局會(huì)同省教育廳、公安廳、省衛(wèi)生健康委聯(lián)合印發(fā)了《安徽省校園食品安全守護(hù)行動(dòng)方案(2020-2022年)》(以下簡(jiǎn)稱《方案》)。為更好落實(shí)《方案》...
2020-11-11 [詳情]
【環(huán)球網(wǎng)報(bào)道】5月22日,第十三屆全國人大三次會(huì)議在人民大會(huì)堂開幕。今年年初,面對(duì)突如其來的疫情,黨中央堅(jiān)持以人民為中心和生命至上,采取一系列果斷重大舉措,...
2020-05-25 [詳情]
為持續(xù)完善食品安全國家標(biāo)準(zhǔn)工作程序,規(guī)范流程文件管理,提高標(biāo)準(zhǔn)工作效率,保障標(biāo)準(zhǔn)工作信息安全,食品安全國家標(biāo)準(zhǔn)審評(píng)委員會(huì)秘書處辦公室(掛靠在國家食品安全風(fēng)險(xiǎn)...
2020-05-06 [詳情]